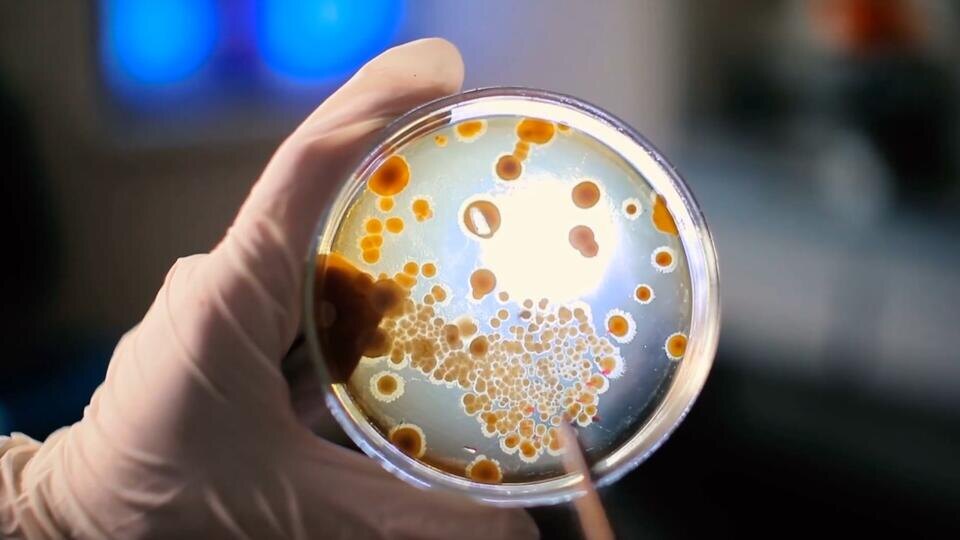

За астрономическую сумму - около 400 тыс. долларов - совсем недавно была продана уникальная реликвия с британского аукциона: послание американского полковника Арчибальда Грейси, пережившего катастрофу. Отправленное в Лондон своему приятелю незадолго до отплытия «Титаника» письмо звучит почти пророчески:
«Это прекрасный корабль, но я подожду окончания путешествия, прежде чем выносить о нем суждение».
Окончательное суждение Грейси вынести не удалось, спустя считанные дни после отправки послания другу, «Титаник» потерпел крушение. Гигантский корабль не выдержал встречи с айсбергом. Именно так звучит одна из официальных версий причин катастрофы.

«Где-то читал что, если бы «Титаник» со всей дури врезался в айсберг носом, то ничего бы этого не случилось. Да, носовые отсеки оказались бы затоплены, да, дорогостоящий ремонт и все сопутствующее, но лайнер остался бы на плаву и, скорее всего, своим ходом добрался бы до гавани. Роковой оказалась команда «переложить руль». Удар оказался скользящим по борту и как нож вспорол половину судна», - пишет в соцсетях Рудольф М. (здесь и далее орфография и пунктуация комментаторов оставлены без изменений – прим. ред.).
О трагической судьбе «Титаника» с момента катастрофы написаны сотни научных исследований, сняты десятки фильмов, как документальных, так и художественных. Однако единого мнения на вопрос «что послужило причиной гибели судна» не было найдено.
Казалось бы, много воды утекло с того далекого 1912 года, но поиски истины не прекращаются. На помощь исследователям пришли цифровые технологии. Недавно специалисты Института судебной экспертизы создали полную компьютерную модель судна и сделали ряд любопытных открытий.

В создании электронной копии легендарного лайнера участвовали специальные глубоководные аппараты «Ромео» и «Джульетта», спустившиеся на глубины Атлантики и запечатлевшие порядка семисот тысяч изображений обломков.
«Мы потратили два года на обработку фото и создание единой точной 3D-модели, позволяющей детально изучить как внешний вид, так и внутреннее устройство судна, погибшего на дне океана», — пояснил ведущий специалист Института судебной экспертизы Станислав Гостищев.
Новая цифровая модель позволила установить одну важную деталь: даже после начала бедствия на «Титанике» продолжало гореть электричество. Открытый клапанный механизм обеспечивала подачу пара к резервному генератору, снабжавшему энергией освещение, обогрев и помпы судна.
Значит, до последних минут экипаж выполнял свою работу, включая техников и кочегаров. Всего в трюме оставались 35 человек команды во главе с главным инженером Джозефом Беллом. Их героическое поведение позволило спасти сотни жизней.

«В темноте началась бы настоящая паника, число жертв значительно возросло бы. Но самое важное: без работающего аварийного генератора прекратила бы функционирование радиостанция. Никто не принял бы сигнал бедствия с тонущего «Титаника», — подчеркнул директор Центра морских симуляций Крис Херн.
Ученые уверены: подавляющее большинство пассажиров и членов экипажа умерли не одновременно с гибелью судна, а от переохлаждения в холодной морской воде примерно за полтора часа до появления спасательного судна «Карпатия».
Количество мест в спасательных лодках оказалось недостаточным для спасения всех пассажиров. Тогда действовала норма расчета количества лодок исходя из водоизмещения судна, а не численности пассажиров. Есть версия, что числом плавсредств пожертвовали ради сохранения эстетики лайнера.
«Да, роковыми были просчёты в проектировании корабля и организации спасения. Шлюпок должно было быть больше, пассажиры натренированы к экстренной эвакуации. Но... всё произошло, как произошло. Сейчас, спустя сотню лет, сидя на уютном диване в тёплой комнате, можно и поразмыслить, как надо было действовать. Нужно было по максимуму, разломав деревянные конструкции - двери например, шезлонги, спускать их на воду и отправлять людей на них дальше от бортов. По максимуму заполнять уже спущенные на воду шлюпки, а отошедшие на безопасное расстояние, увязывать меж собой в более грузоподъёмные плоты... все мы крепки задним умом, а тогда у людей было лишь полтора часа и безбрежный холодный океан на сотни миль вокруг», - считает Владимир М.
Исчерпывающие подробности столкновения с айсбергом удалось восстановить благодаря компьютерной визуализации.
Оказывается, удар был скользящим и занял всего шесть секунд. После удара в правом борту образовалась серия маленьких отверстий общей площадью меньше альбомного листа.
Несмотря на значительные повреждения четырех передних секций, судьбу «Титаника» решили именно два небольших разрыва возле наиболее пострадавшего участка, приведшие к быстрому затоплению остальных помещений.
Именно этот фактор мог привести к немедленному повреждению сразу шести отсеков, лишив корабль шанса сохранить плавучесть.
Финальный раскол произошел прямо на поверхности, а не вследствие удара о грунт, как предполагалось ранее. Причиной тому стало низкое качество использованных при постройке железных заклепок, которые теряли прочность при низких температурах.
По словам выживших очевидцев происшествия, уход «Титаника» под воду сопровождался серией взрывов. Компьютерная визуализация позволила дать научное подтверждение этим свидетельствам.
Ученые обнаружили искажение стенок паровых котлов с вдавленными внутрь поверхностями. Горячий котел, соприкасаясь с холодной водой, быстро остывал, вызывая образование вакуума и мгновенное разрушение металлических конструкций.

«Это явление привело к мощным звуковым эффектам, воспринимавшимся как мощные удары, похожие на взрывы», — утверждает эксперт Гостищев.
Обломки «Титаника», находящиеся на огромной глубине в 3800 метров, содержат бесчисленные предметы, принадлежавшие пассажирам. Среди них — фарфоровая посуда, драгоценности, одежда и даже редкий экземпляр стихотворений Омара Хайяма, украшенный золотом и изумрудами.
Однако важнейшим достоянием являются семь миллионов писем, хранящих личные истории жителей прошлого века.
«Читал, что «Титаник» специально направили на айсберг. Он должен был погибнуть, так как компания-судовладелец была на пороге банкротства, и только огромная страховая сумма могла спасти её. «Титаник» был застрахован, но погиб в первом же рейсе, он специально вошёл в район движения айсбергов, а не должен был туда заходить. Сильно уклонился от надлежащего курса. Так вести корабль мог только дилетант, а капитан Смит дилетантом не был, но хозяева обязали его идти этим курсом. Ничего особенного - обыкновенный капитализм», – рассуждает один из интернет-пользователей.
Сегодня любые попытки извлечь на поверхность предметы с затонувшего лайнера запрещены международными организациями.
«Это подводный мемориал, который хранит память о полутора тысячах погибших людей. Данный памятник охраняется ЮНЕСКО, законами Великобритании и Соединенных Штатов Америки, которая, в первую очередь, блокировала по своим законам поднятие оттуда каких-либо документов и вещей», – подчеркивает Гостищев.
Специалисты отмечают, что сам «Титаник» постепенно теряет свою физическую форму: около 30 видов микроорганизмов активно «работают» и перерабатывают металлические фрагменты судна, съедая ежедневно до 180 кг материала.
Вероятно, в ближайшие 50 лет следов от лайнера практически не останется. Впрочем, точные цифровые модели позволяют современным исследователям сохранять уникальные сведения о судьбе легендарного "Титаника".
